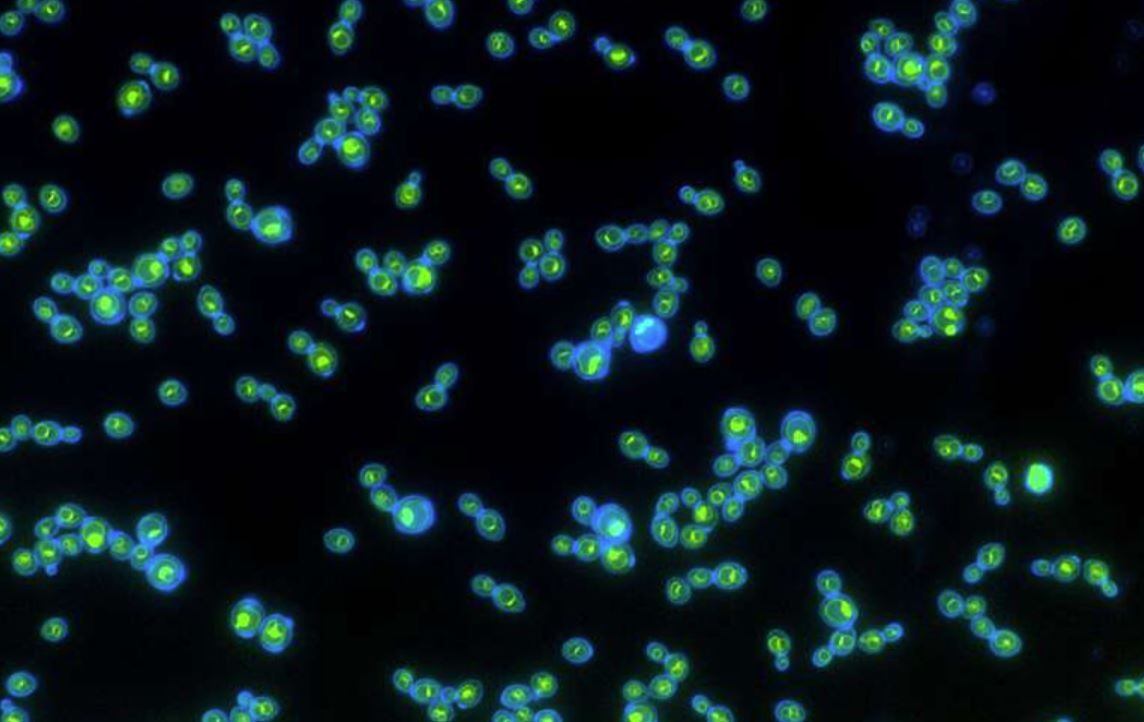

Lucha contra las superbacterias en Argentina: un encuentro científico busca cómo combatir la resistencia antimicrobiana

La resistencia antimicrobiana (RAM) es una preocupación creciente a nivel mundial, exacerbada por el uso excesivo de antibióticos y plaguicidas, lo que afecta la diversidad del microbioma humano.
Un estudio reciente publicado en The Lancet advierte que, sin medidas urgentes, países como Argentina e India podrían enfrentar un aumento significativo en la mortalidad por infecciones resistentes a los antibióticos para 2050.
Por esta razón, investigadores del Hospital Italiano y el CONICET están tomando medidas para evitar que Argentina se convierta en uno de los países más afectados por las muertes causadas por superbacterias para el año 2050.

En un esfuerzo por abordar esta amenaza, el 21 de octubre se llevará a cabo el “Simposio de Ciencia Ciudadana: Relación entre Plaguicidas, Microbiota, Resistencia Antimicrobiana y Enfermedades” en el Centro Cultural de la Ciencia en Buenos Aires, según informaron los organizadores del evento.
El simposio, organizado por el Hospital Italiano y el Consejo Nacional de Investigaciones Científicas y Técnicas (CONICET) , busca reunir a científicos, emprendedores y ciudadanos interesados en los efectos del uso indebido de antibióticos y plaguicidas. La médica epidemióloga Silvana Figar, organizadora del evento, enfatizó la importancia de cambiar la mentalidad hacia una interacción más armoniosa con las bacterias, en lugar de combatirlas agresivamente.
“Buscamos promover un cambio de mentalidad en la forma en que se aborda la resistencia antimicrobiana. Hoy, gracias a la investigación científica moderna, comprendemos que es más beneficioso ‘danzar con las bacterias’ que combatirlas”, explicó Figar, que adelantó que la realización del simposio se enmarca en las II Jornadas de Investigación e Innovación del Hospital italiano y se celebrará en el Centro Cultural de la Ciencia (en la sede del Conicet).
La RAM, agravada por el uso excesivo e indebido de antibióticos y otros químicos, plantea una de las amenazas más críticas para la salud pública mundial porque daña la diversidad del microbioma. Las infecciones que hoy en día son tratables podrían convertirse en letales si la farmacorresistencia continúa su acelerada propagación.
Este problema sanitario fue uno de los temas de la 79 Asamblea General de las Naciones Unidas, evento que reunió expertos de todo el mundo donde participó Figar como representante de ReAct Latinoamérica, una organización internacional que trabaja en red sobre las consecuencias de la RAM y promueve abandonar la metáfora de guerra contra las bacterias.
La microbiota, el conjunto de microorganismos que habitan en el cuerpo humano, especialmente en el intestino, juega un papel crucial en la digestión, la función inmune y la protección contra patógenos. Menos del 0,1% de estos microorganismos son dañinos para los humanos. Sin embargo, el equilibrio de este ecosistema puede verse alterado por el uso excesivo de plaguicidas y antimicrobianos, lo que contribuye al desarrollo de bacterias resistentes. Proteger la biodiversidad microbiana es una estrategia preventiva clave para mejorar la resiliencia de la salud humana y prevenir infecciones graves.

“El simposio está diseñado para reunir a científicos, emprendedores y ciudadanos interesados en los efectos del mal uso de los antibióticos y plaguicidas en la salud pública, así como en la prevención de enfermedades mediante el cuidado de la microbiota, un ecosistema microbiano fundamental para el bienestar humano. Luego de una ronda de evidencias científicas y experiencias de vinculación entre el mercado y la ciencia, realizaremos un Hackaton entre todos los sectores, incluyendo a la ciudadanía, para pasar a la acción”, agregó Figar.
El evento incluirá una ronda de evidencia científica, donde expertos presentarán investigaciones sobre la relación entre plaguicidas, microbiota, resistencia antimicrobiana y varias enfermedades. También habrá una ronda de oportunidades para discutir experiencias de mercado sostenibles que prioricen la salud comunitaria y el cuidado ambiental. Finalmente, se realizará un hackatón para generar ideas y proyectos que promuevan el cuidado de la microbiota y la lucha contra la RAM, bajo el enfoque de Una Sola Salud, que integra la salud humana, animal y ambiental.
“La colaboración entre microorganismos es la base de la vida, y nuestra capacidad para interactuar de manera creativa con este complejo ecosistema microbiano es clave para el futuro de la salud global. El evento busca promover un cambio de mentalidad en la forma en que se aborda la resistencia antimicrobiana. Durante siglos, la ciencia ha visto a las bacterias patógenas como enemigos, desde ese enfoque era esperable pensar que había que combatirlas”, concluyó Figar.
La fundación Pollera – Pantalón acompaña esta iniciativa difundiendo el valor de la misma. “La inscripción ya está abierta a todos los interesados, sean organizaciones o personas individuales y por un tema de espacio es necesario anotarse”, detalló Figar, que además investigadora del CONICET y coordinadora del Área de Investigación en Salud Poblacional de la Secretaría de Investigación de la Universidad Hospital Italiano.

Estructura del simposio
El evento estará organizado en tres secciones clave:
· Ronda de evidencia científica: Expertos de diversos campos presentarán investigaciones y experiencias que exploran la compleja relación entre plaguicidas, microbiota, resistencia antimicrobiana y enfermedades.
· Ronda de oportunidades: Un espacio de intercambio entre empresas, organizaciones y representantes sociales para discutir experiencias de mercado sostenibles que prioricen la salud comunitaria y el cuidado ambiental.
· Hackatón: Un espacio interactivo en el que ciudadanía, ciencia y sector empresarial se vincularan para generar ideas y proyectos que promuevan el cuidado de la microbiota y la lucha contra la RAM, bajo el enfoque de Una Sola Salud (One Health), que integra la salud humana, animal y ambiental.
Toda la información del evento está disponible en la web del CONICET donde además se encuentra el link al formulario online para quien quiera anotarse.




